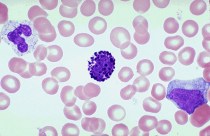
basophils

Hello Internet! No, I missed you more. Let’s chat about allergies shall we
Let me set the scene…

It’s a beautiful morning in March. No scratch that, it’s a perfect morning. It’s the kind of day that wakes you up before your alarm clock and you are surprisingly ok with it. You’re even singing in the shower (if I don’t sing in the shower I don’t feel quite as clean). So you kick the door open to get outside and get this day started when it hits you, allergies, Mother Nature’s “you don’t belong here” bitch slap to the senses.
First it’s a sneeze, a harmless little sneeze that triggers 3 more sneezes. Then your nose starts to run in that “get me a Kleenex or I’m wiping it on my sleeves and I don’t care who sees me” kind of way. Of course, the last straw…the absolute take me out back and put me out of my misery moment is when the eyes start their itchy, watery awfulness. So you look around to see if this is happening to anyone else…if anyone is hurt…if there is a special report on channel 6 about bio-terrorism attacks in your neighborhood. No one else seems to be effected and it’s not terrorists or a demon possession. Here’s what happens…

I’m fine! It’s just allergies ok.
The Super Condensed Cliff Notes Version
Allergens in the environment stimulate our B-cells to produce IgE that builds up in our bloodstream eventually attaching to Mast cells and basophils. Upon subsequent exposure, the allergens bind to the membrane bound IgE on the surfaces of the Mast cells and Basophils triggering the release of histamine filled granules, initiating the localized inflammatory response we all love to hate.
Your White cells are angry (localized immune response to allergens)
Alright I’m sorry but I’ve got to review a few things with you people.We learned as kids that our blood is composed of red cells that carry oxygen and white cells that help fight infections. The truth is we have a variety of white cells (leukocytes) that each has its own, nifty G.I. Joe-like skills at combat. Let me draw your attention to 3 cells for now; B-lymphocytes, basophils, and mast cells.
Your B-cells A.K.A B-lymphocytes develop from stem cells in the bone marrow and later hang out in the lymphatic organs (like your lymph nodes) where they are educated in the ways of antigen recognition (sort out the good from the bad) and are armed with the black magic ability to produce antibody for whatever ails you.
If you recall, antigens refer to any substance that can elicit an immune response. Antigens can be composed of carbohydrates, lipids, proteins, or anything that triggers the cascading effects of your immune cells (leukocytes) when they come into contact with it.
Antibodies are highly specialized, fancy-pants proteins produced by B-lymphocytes that have the ability to bind to the antigens of foreign invaders (pathogens) that slip into the bloodstream (Bacteria, viruses, microscopic fungi). The pathogens that invade our bodies display antigenic molecules on their surfaces, which is how they get spotted in the first place. If our B-cells make antibody that fits that antigen molecule (which it pretty much always does) our white cells will begin beating down that pathogen in a large-scale battle royale that involves cell divisions and some serious Pacman-like chomping action.
That’s right, your white cells divide and conquer. That’s why doctors are often expecting your white cell count to be elevated during and infection. They are quite literally forming a clone army.
When they bind to a pathogen it allows white cells like macrophages to engulf them and also facilitates the killing action of another class of bad-ass, ninja protein referred to as complement that are always present in your bloodstream.
Our antibodies come in a variety of shapes, sizes, and classes based on complexity and specificity.
Keep in mind that there is a lot of crap floating around in the air, hanging out on table tops, Bank door knobs, and wherever 4 yr olds are running around, sneezing without covering their mouths.

Best Summer ever!
These microbes are just looking for their 15 minutes of fame and a chance to raise hell in our blood stream like a Girls Gone Wild, MTV beach house weekend.
So with so much diversity B-cells produce a very generalized, one size fits all, meat and potatoes class of antibody referred to as IgM. The structure of this antibody has a lot of arms that are well suited for grabbing hold of more than one antigen at the same time. Then there is the more specific IgG that gets produced in response to repeat offenders, meaning the body built up immunity to that invader and set aside memory b-cells armed to the teeth with antibody “made to order” for subsequent invasions.

Uh yeah, that’s real clear. So those star fish looking things are the IgM antibodies and they help that enormous white cell to grab hold of whatever nasty bug they attach to
Let’s get back to Allergies!
that handsome devil in the center is the basophil. White cells are actually colorless until a stain is added to the slide. Basophils stain in basic (alkaline) pH, thus baso-phil.
When it comes to allergic responses IgE class antibodies are the usual suspects. They have the ability to activate distinct white cells in our body (Basophils in our blood and mast cells in our tissues) Both of these cells contain granules that when freed from their cellular cages unleash a potent substance called histamine which is primarily responsible for the classic symptoms of an allergic response. Your mast cells and basophils like to hang out on the mucous membranes of the nose, ears, throat, and eyes. These are the access points to your body, places of direct exposure to the outside environment. So these groupings of immune cells are just more likely to have a few run ins anyway with bad boys looking for a fight.
Behind the Scenes

D-awww adorable!
Let’s say you’re frolicking through the fields one day like a happy Jack Russell terrier, kick up some ragweed pollen and think nothing of it. For whatever reason ragweed pollen just rubs your white cells the wrong way (meaning white cells possess a membrane receptor that matches the antigenic determinant of the pollen granule and become sensitized on contact). Over the next few weeks your body will produce a line of B-cell clones that will only produce IgE for that pollen strain which will circulate in your blood stream attaching itself to the membranes of Basophils and Mast cells.

I mean if it’s a choice between land mines and funnel cake I choose cake not war.
These cells literally get coated in IgE like powdered sugar on funnel cake (man that sounds really good right now). So the next time that you’re exposed to ragweed pollen the IgE on those cell membranes grabs a hold of the antigen and triggers the basophils and mast cells to release their histamine granules like land mines.
When Histamine Attacks
The histamine released by your white cells acts on the cells of capillaries. It increases their permeability, opening up the blood vessels allowing white cells and plasma proteins access to the site of infection. This is what we call inflammation. So allergic responses to allergens are an inflammatory process. In the case of a runny nose it is the histamine released by mast cells in your nasal cavity acting on the vessels in your nose. The histamine molecule only has about 17 atoms so it passes quite easily through cellular membranes. A good portion of cold, sinus, and seasonal allergy medications available in the pharmacy section of your grocery store are “antihistamines” counteracting the effects of histamine to relieve your symptoms.
Anaphylaxis
So unfortunately the occasional runny nose isn’t all that allergic responses are capable of and in a select percentage of the population the triggering of inflammation can be a critical and often fatal, systemic reaction. I’m referring to anaphylaxis. This process reflects the most extreme form of immediate immune response whereby widespread inflammation can lead to severe swelling of the eyes, constriction of airways and even shock where the blood pressure drops. Yes, well you know how I like to end things on a light note so….take a look at this beagle puppy playing with a stuffed animal.

Stay curious, stay classy, and never stop learning my friends 🙂